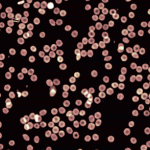
Flowing RBC imaged at 20x using the Digital Holographic Camera Flowing RBC imaged at 20x using the Digital Holographic Camera

The Digital Holographic Camera is a cost-effective module that can readily be attached to the side port of your fluorescence microscope. It allows to easily obtain phase images from a standard fluorescence microscope with a simple module addition.
News, events, promotions, webinars
If you are already equipped with a fluorescence microscope you don’t need to get a full standalone DHM® to gain the advantages of label-free imaging. Simply mount the Digital Holographic Camera module to one of your microscope’s side port to obtain the full benefit of non-invasive quantitative phase imaging.
The Digital Holographic Camera 5 Mpixels camera provides a 4X larger field of view compared to standard imaging devices with a higher spatial and temporal resolution. Thus allowing to quantify fine and fast changes occurring in your sample in a completely non-invasive way.
Technical Features
- Large field of view: 1.2*1.2 mm (at 10x)
- Camera: 5 Mpixels sCMOS sensor
- High acquisition speed: up to 75 fps
- System dimension: 50*20*20 cm
- Magnification: from 5x to 100x
- Lateral resolution: MO dependent